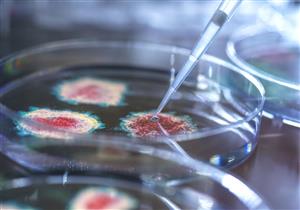
بالكمامة والمعقم.. هكذا تحمي نفسك من الإصابة بسلالة كورونا الجديدة

أخبار متعلقة بــ
المملكة المتحدة
-
من حيث الإصابات والوفيات.. تعرف على الدول الأكثر تضررًا من فيروس كورونا

تجاوز عدد الإصابات بفيروس كورونا المستجد (كوفيد 19) حول العالم، أكثر من 150 مليون شخص
-
سوبر كوفيد.. اكتشاف سلالة جديدة من كورونا في بريطانيا

أعلنت الحكومة البريطانية، عن اكتشاف سلالة جديدة من فيروس كورونا المستجد، تعرف باسم "سوبر كوفيد"، في اسكتلندا ومقاطعة غلوسيسترشير جنوبي غرب إنجلترا.
-
دراسة غريبة.. حقن الشباب في بريطانيا بفيروس كورونا عمدًا

أعلنت المملكة المتحدة، أنها بصدد إجراء دراسة، حيث سيتم خلالها حقن عدد من المتطوعين، تتراوح أعمارهم بين 18 و30 عامًا، بفيروس كورونا المستجد، حتى يستطيع العلماء فهم كيفية انتشار الوباء بشكل أكثر عمقًا.
-
"محض أسطورة".. طبيب روسي شهير يفجر مفاجأة عن سلالة كورونا الجديدة

زعم ألكسندر مياسنيكوف، الطبيب الروسي الشهير، أن السلالة الجديدة من فيروس كورونا المستجد، المكتشفة في المملكة المتحدة، نهاية العام الماضي، ما هي إلا "أسطورة".
-
الآثار الجانبية للقاح كورونا.. هل يدل ظهورها بعد التطعيم على عدم سلامته؟

عانى بعض الحاصلين على لقاح كورونا في المملكة المتحدة من آثار جانبية بعد التطعيم، شملت "ألم في موضع الحقن والصداع والإرهاق والغثيان والدوخة وآلام المفاصل والعضلات".
-
بلد المليون مصاب.. سلالة كورونا الجديدة تسجل أرقام صادمة في بريطانيا

صرح وريس جونسون، رئيس الوزراء البريطاني، بأن عدد المصابين بفيروس كورونا المستجد في إنجلترا حاليًا، تجاوز حاجز المليون حالة، بعد تسجيل 60916 إصابة، أمس الثلاثاء.
-
سيغير قواعد اللعبة.. لماذا يتفوق لقاح أسترازينيكا على "فايزر" و"موديرنا"؟

أكدت صحيفة "فايننشال تايمز" البريطانية، أن اللقاح الذي طورته شركة "أسترازينكا" بالتعاون مع جامعة "أكسفورد"، سيغير قواعد اللعبة في مكافحة فيروس كورونا المستجد حول العالم.
-
ظهور سلالة كورونا الجديدة بثلاث دول عربية.. تعرف عليها

أعلنت وزارة الصحة الأردنية، اليوم الأحد، عن ظهور سلالة كورونا الجديدة في البلاد، موضحةً أنه تم العثور عليها عند مواطنين قادمين من المملكة المتحدة.
-
التحور مستمر.. اكتشاف سلالة جديدة من كورونا في نيجيريا

أعلن جون نكينغاسونغ، رئيس المراكز الإفريقية لمكافحة الأمراض والوقاية منها، عن ظهور سلالة جديدة من فيروس كورونا المستجد في نيجيريا.
-
بالكمامة والمعقم.. هكذا تحمي نفسك من الإصابة بسلالة كورونا الجديدة
صارت سلالة كورونا الجديدة التي تم اكتشافها مؤخرًا في المملكة المتحدة، مصدر قلق لجميع سكان العالم، خاصةً بعدما أفادت منظمة الصحة العالمية بأنها أكثر قدرة على الانتشار بين البشر، ولكنها لا تسبب درجة أشد من المرض.
-
"الصحة العالمية" تحسم الجدل بشأن فعالية لقاحات كورونا ضد السلالة الجديدة

يرجع بسبب اهتمام الصحة العالمية بالسلالة الجديدة إلى أنها تحتوي على مجموعة من التغيرات، والإشارات الأولية تفيد بأنها قد تكون أكثر قدرة على الانتشار بسهولة بين الناس.
-
حظر الرحلات الجوية.. هكذا ستواجه الدول الأوروبية سلالة كورونا الجديدة

خروج السلالة الجديدة من فيروس كورونا المستجد عن السيطرة بالمملكة المتحدة، كما أعلن مات هانكوك، وزير الصحة البريطاني، دفع العديد من الدول حول العالم، إلى إعلان حالة الطوارئ واتخاذ التدابير الوقائية اللازمة للتصدي لها.
-
بعد ارتفاع الإصابات مرة أخرى.. هل تواجه بريطانيا موجة ثانية من كورونا؟

في الوقت الذي تستعد فيه بريطانيا لرفع الحجر وفتح الحانات والمطاعم وصالونات تصفيف الشعر والمتاحف ودور السينما في مطلع يوليو، بعد إغلاقها منذ نهاية مارس، نشر ممثلو الأوساط الطبية رسالة مفتوحة في مجلة "بريتيش ميديكال جورنال"
-
إنجلترا تعلن عن أولى حالات الإصابة بفيروس كورونا

ضرب فيروس كورونا القاتل المملكة المتحدة اليوم، حيث أثبتت الاختبارات أول حالتين مصابتين بالفيروس.
-
بذرة مغناطيسية تغني مرضى سرطان الثدي عن الجراحة الثانية

تحتاج النساء اللاتي يخضعن لجراحة سرطان الثدي، بنسبة 25%، لإجراء جراحة ثانية، ويعد ذلك ضروريًا في حال عدم استئصال الورم بشكل كامل في الجراحة الأولى.
- المزيد
إعلان
مختارات لا تفوتك
-
 أخبار صحة
أخبار صحةوزارة الصحة: العلاج المناعي يعزز بروتوكولات علاج سرطان الثدي في مصر
وزارة الصحة. العلاج المناعي. بروتوكولات علاج سرطان الثدي. سرطان الثدي. علاج سرطان الثدي في مصر. تطوير علاج سرطان الثدي. الكشف المبكر للمرأة. دعم صحة المرأة.
-
 نصائح
نصائحالعنب في الصيف- ماذا يحدث لمريض ارتجاع المريء عند تناوله؟
العنب في الصيف. العنب لمرضى ارتجاع المريء. العنب والارتجاع المريئي. العنب وارتجاع المريء. العنب وارتجاع المرئ. العنب والحموضة. العنب والمريء. العنب والحموضه.
-
 نصائح
نصائحالغثيان بعد أكل البيض.. تعرف على سببه وكيفية التخلص منه
البيض يسبب غثيان. البيض والقيء. البيض والغثيان. الغثيان بعد أكل البيض. سبب الغثيان بعد أكل البيض. اسباب الغثيان بعد اكل البيض. علاج الغثيان بعد اكل البيض.
-
 أخبار مطبخك الصحي
أخبار مطبخك الصحيوجبة الإفطار لمرضى القولون العصبي- إليك الأطعمة الممنوع تناولها صباحًا
وجبة الفطور لمرضى القولون العصبي. وجبة الفطور لمرضى القولون. وجبة فطور لمرضى القولون العصبي وجبة الافطار لمرضى القولون وجبة الافطار لمرضى القولون وجبة افطار لمرضى القولون
-
 نصائح
نصائحقبل تلف الأعصاب- إليك الأعراض الأولية لنقص فيتامين B12 بالجسم
نقص فيتامين B12. علامات نقص فيتامين B12. أعراض نقص فيتامين B12. نقص فيتامين B12 والأعصاب. أعراض نقص فيتامين B12 على الأعصاب. تأثير نقص فيتامين ب12 على الأعصاب.
-
 نصائح
نصائحأسباب الدوخة عند حركة الرأس- هل تستدعي زيارة الطبيب أم لا؟
الدوخة عند حركة الرأس. الدوخة مع حركة الراس. الدوخة عند تحريك الرأس. اسباب الدوخه مع حركه الراس. أسباب الدوخة عند حركة الرأس. سبب الدوخة مع حركة الراس.
-
 نصائح
نصائحسبب خروج البراز على شكل خيوط- طبيب يوضح الأمراض المحتملة
خروج البراز على شكل خيوط الامراض براز على شكل خيوط. سبب خروج البراز على شكل خيوط. اسباب نزول البراز على شكل خيوط. نزول البراز على شكل خيوط. سبب نزول البراز على شكل خيوط.
-
 أمراض مزمنة
أمراض مزمنةطبيب يحذر: هذا السعال علامة على وجود مشكلة في عضلة القلب
سعال مريض القلب. مريض القلب والكحة. مريض القلب والكحه. كحة مريض القلب. السعال بسبب القلب. الكحه وعلاقتها بالقلب. السعال القلبي. الكحة القلبية. امراض القلب والكحة.
-
 صور و فيديوهات
صور و فيديوهاتمحمد صلاح في كأس العالم- هل يلحق بمباراة أستراليا؟ "فيديوجرافيك"
إصابة محمد صلاح. موقف محمد صلاح من المشاركة في مباراة أستراليا. محمد صلاح في كاس العالم. محمد صلاح في كأس العالم. منتخب مصر في كاس العالم. منتخب مصر في كأس العالم 2026.
-
 صور و فيديوهات
صور و فيديوهاتوفاة طفل في سيارة والده- إليك تفاصيل القصة "فيديوجرافيك"
مأساة التجمع. وفاة طفل في سيارة والده. وفاة طفل داخل سيارة. أب ينسى طفله. أب ينسى طفله داخل سيارة. ضحية النسيان حمزة. الطفل حمزة ضحية النسيان. حمزة ضحية النسيان.











